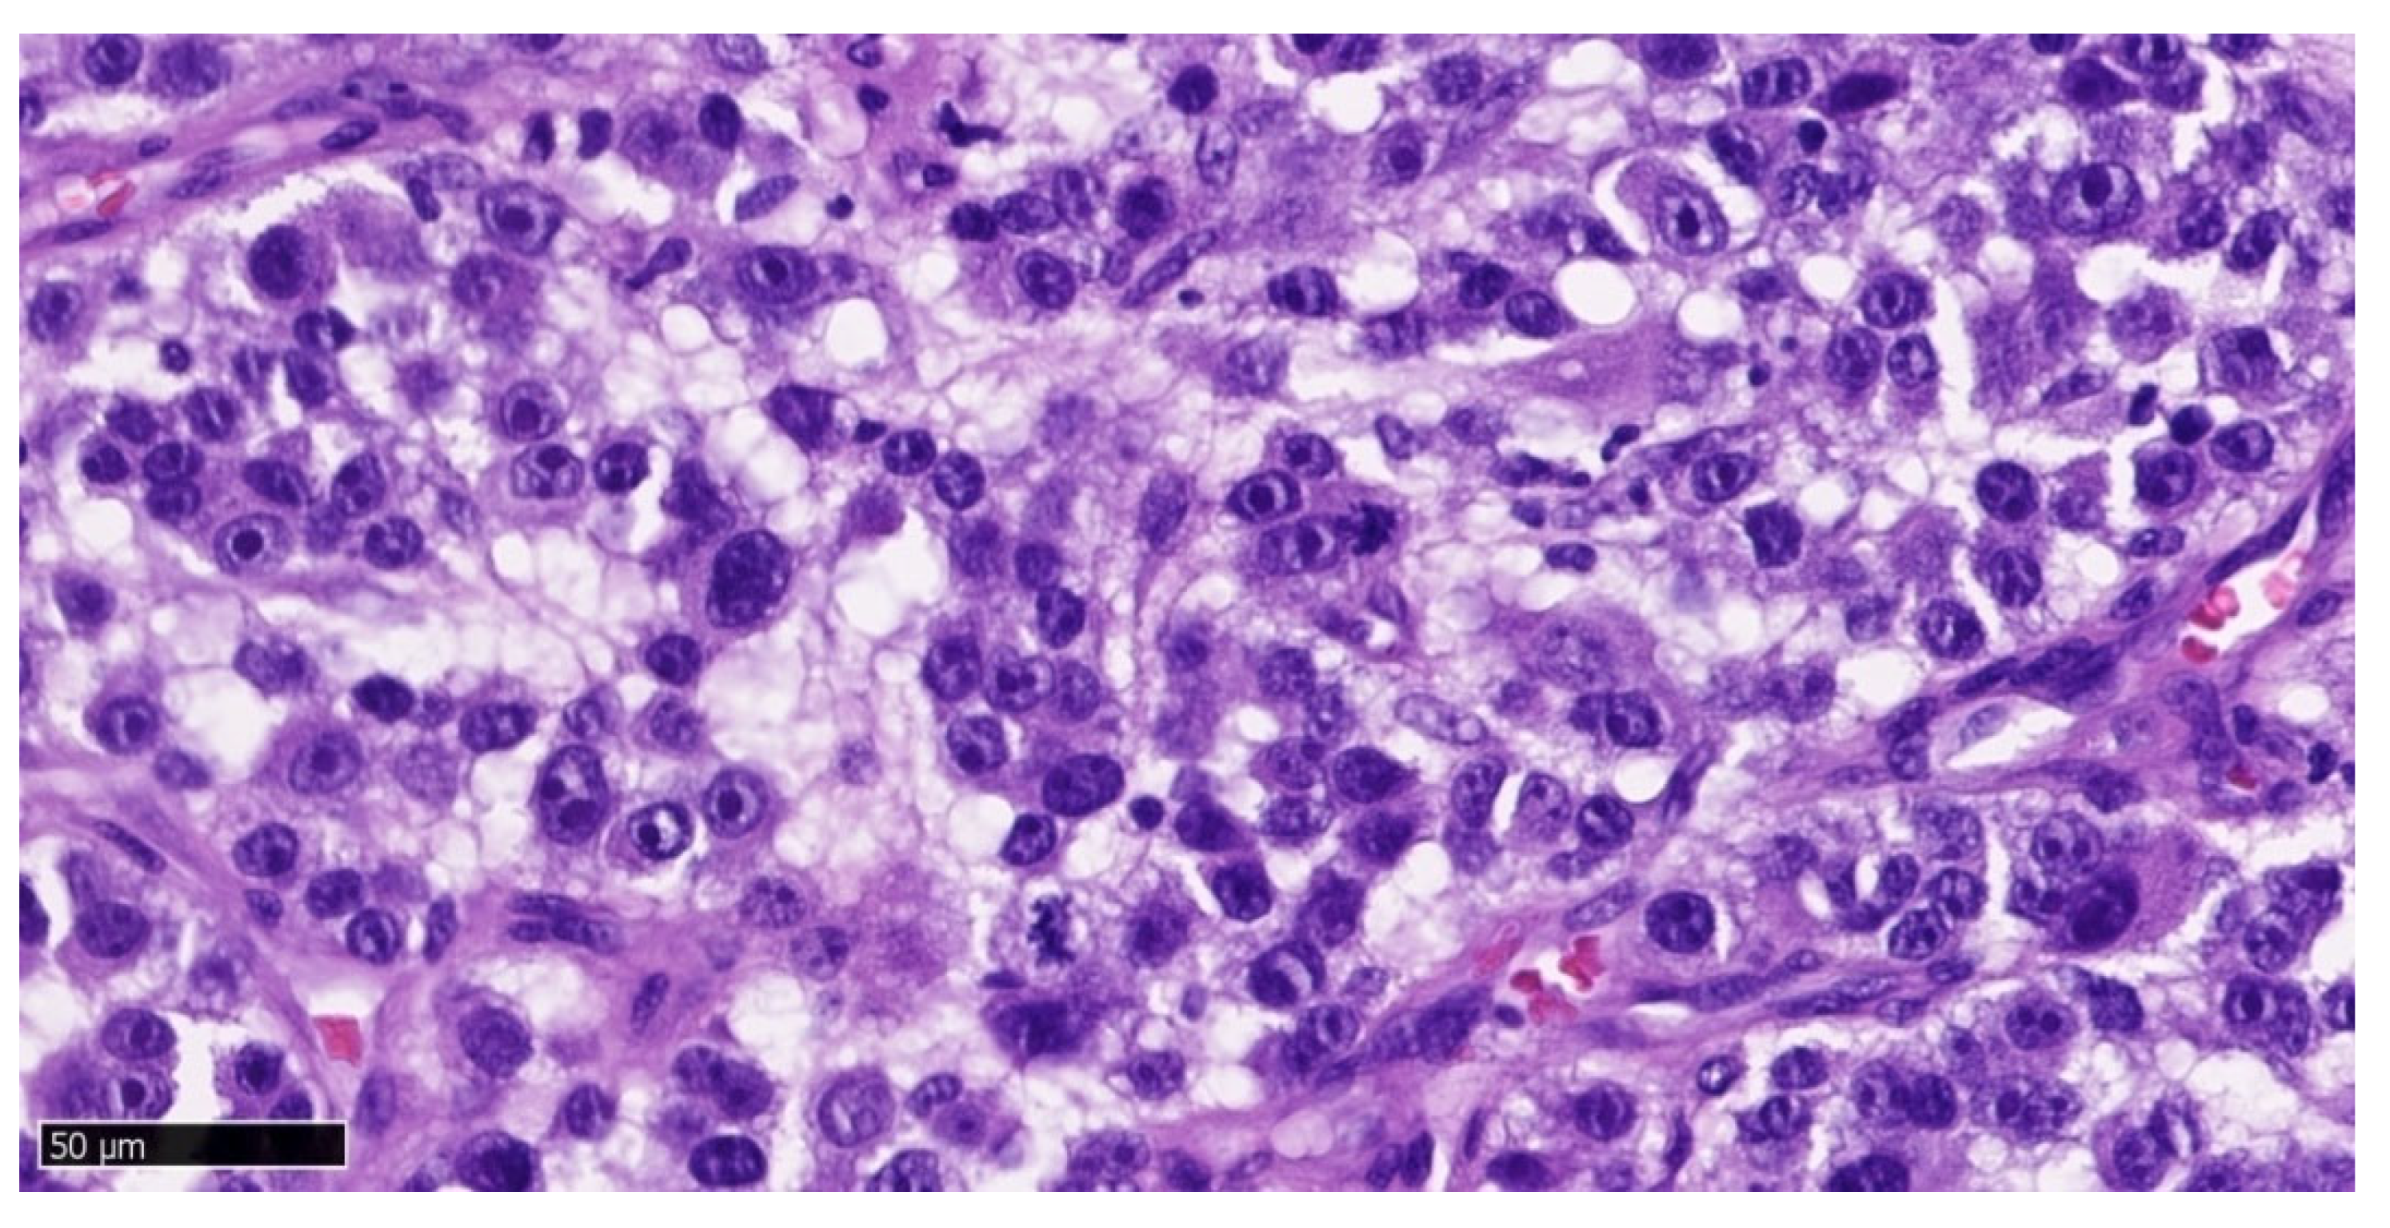
Preprints 169129 g005

1. Introduction
Primary oral mucosal melanoma (OMM) is an extremely rare tumor, accounting for 1-2% of all malignant tumors of the oral cavity and less than 1% of all melanomas. Its incidence increases with age, and most patients are over 60 years old (median age at diagnosis is 70 years) [
1]. It is more common in men [2- 4] and is more prevalent in the indigenous Japanese, African, and American populations, than in the white race [
5]. The etiology of oral mucosal melanoma is unknown: there is no evidence that repeated trauma, chronic inflammation or smoking play any role in its pathogenesis [
5]. It has been ruled out that ultraviolet radiation or association with SMV, EBV, HPV, HSV viruses affect the incidence of OMM [
1]. The only confirmed risk factor is the previous occurrence of melanin hyperpigmentation sites in the mucosa [
5]. Most OMMs arise de novo from clinically normal mucosa, but about 30% of cases are preceded by oral pigmentation for several months or even years [5- 7].
About 40% of mucosal melanomas are amelanotic (in the case of cutaneous melanoma malignum - MM - 10%) and in 20% of cases they occur multifocally (MM - 5%) [
8].
About 80% of primary melanomas located in the oral cavity occur in the keratinized mucosa of the hard palate, then the mucosa of the maxilla and mandible and the buccal mucosa. Cases of melanoma of the tongue or bottom of the mouth [
7,
9] and lips, soft palate, retromolar triangle [
10] have also been described. Only 0.6-9.3% of patients with cutaneous melanoma will develop metastases in the mucosa of the upper gastrointestinal tract [
11]. Metastases of melanoma to the oral cavity are rare, most often located in the bones of the maxilla and mandible and on the tongue, and their appearance may indicate systemic spread of the tumor [
12]. At the time of diagnosis of oral mucosal melanoma, metastases to regional lymph nodes can be observed in about 25% of patients, and distant metastases in about 10% [
5]. They are most often observed in the lungs (54%), liver (35%) and bones (25%). In the case of the cutaneous form (MM), metastases are most often diagnosed in the skin (13-38%), lungs (18-36%) and lymph nodes (5-34%) [
1].
In two-thirds metastases arise by the lymphatic route, in the remaining part by the hematogenous route [
13].
When examining the histopathology of oral mucosal melanoma the depth of infiltration is not assessed on the Clark and the Breslow scale, due to architectural differences between the oral mucosa and the skin. The oral mucosa is thinner than the skin and does not have histological reference points like the skin: the papillary and reticular layers [
14]. In addition, no difference in prognosis was found in patients with mucosal melanoma depending on the depth of infiltration [
27].
In the case of the cutaneous form of melanoma (MM) mutations in the BRAF gene occur in about half of the patients, while in mucosal melanomas they were identified in only a small number of patients (3-11% of mucosal melanomas have BRAF mutations, and 5-14% NRAS mutations) [
1]. Due to the aggressive course, only stages III and IV are distinguished in the AJCC TNM classification (
Table 1.).
The ABCD checklist, which is commonly used in the process of identifying cutaneous melanoma, can also be helpful in diagnosing oral melanoma [
6]:
A - asymmetry - irregular shape and color
B - borders - uneven and jagged edges
C – color- varied color
D - diameter - greater than 6 mm (dynamics)
E - elevation or evolution - of the surface above the level of the surrounding epidermis.
Xavier-Junior et al. proposed the use of the AEIOU acronym to systematize the characteristic features of oral mucosal melanoma [
15]. They present the mentioned criteria as follows:
A - age - over 50 years,
E - ethnicity - referring to the predisposition to the occurrence of lesions in Asian, Latino and African races,
I - irregularity - of changes in terms of color and shape of their edges,
O - oral palate - predilection to occur in the palate area,
U - ulceration - ulcers that may accompany the lesions.
According to Tanaka et al., oral mucosal melanomas can be divided based on their clinical appearance into five types:
1) nodular pigmented,
2) nodular non-pigmented,
3) macular pigmented,
4) mixed pigmented,
5) mixed non-pigmented [
2].
Initially, oral mucosal melanoma develops asymptomatically, but very dynamically. The early stage of the disease is a small, usually flat lesion. Over time, the tumor becomes more and more convex and irregular. It can have various colors: black, brown, gray, purple, red, and even white. The appearance of satellite eruptions and symptoms of inflammation such as peripheral erythema around the lesion is observed. Late symptoms of oral mucosal melanoma are bleeding from the tumor, loosening of the teeth, firm consistency of the tumor and the surrounding lymph nodes enlarge, forming hard and board-like lesions. Ulceration of the tumor surface is common [2, 16]. The boundaries of the tumor are usually irregular and there is no clear demarcation between it and the adjacent tissues [
17].
Greene et al. proposed three criteria for the diagnosis of primary OMM:
demonstration of malignant melanoma in the oral mucosa
the presence of so-called 'junctional activity' (i.e. melanocytes distributed along the basal layer of the surface epithelium) in the lesion
the inability to demonstrate malignant melanoma in any other primary site
However, the presence of 'junctional activity' is now considered an unreliable indicator that the lesion is primary, as melanoma metastases can also show it [
6]. Primary melanoma cells derived from immature melanocytes residing in the lamina propria can proliferate and deeply infiltrate without resembling 'junctional activity'. If Green's assumptions were true, then in a patient with cutaneous melanoma who subsequently developed melanoma in the oral cavity, it must be considered as metastasis. However, it may be an independent second primary tumor. Therefore, histopathological examination cannot assess whether the examined lesion is primary or metastatic. Only genetic and molecular studies can resolve this uncertainty, but this issue seems to be academic rather than practical [
5].
Histologically, amelanotic oral mucosal melanoma consists of spindle cells with many mitotic Figure s and no cytoplasmic melanin pigmentation. These malignant tumor cells are characterized by significant pleomorphism with large, irregular hyperchromatic nuclei and prominent nucleoli [
18]. The cells of malignant oral mucosal melanoma can be demonstrated by hematoxylin and eosin staining. However, if melanin is not present in amelanotic melanoma, immunohistochemical staining should be performed to obtain further information. CK and LCA staining are used for differential diagnosis with squamous cell carcinoma and lymphoma. Immunohistochemical markers useful for the diagnosis of OMM are MART-1/Melan-A, HMB-45, MITF, tyrosinase and S-100 protein. However, since their sensitivity and specificity are not absolute, no single marker should be relied upon, but a series of tests should be performed to confirm the diagnosis of oral mucosal melanoma [
5].
Sometimes satellite nodules can occur, i.e. nests of tumors, separated from the main body of the lesion. They are more common in the cutaneous form of melanoma than in mucous membranes. Their occurrence is associated with a worse prognosis [
19].
Computed tomography (CT) with contrast is used to assess the primary tumor and cervical lymph nodes. Also, it shows bone lesions. Magnetic resonance imaging (MRI) is used to diagnose melanoma in soft tissues and is useful for assessing the extent of tumors of the paranasal sinuses, especially those that may involve the base of the skull and/or show neurotropic spread. Tests to detect distant metastases include brain MRI, chest CT, bone scintigraphy and/or PET [
20]. The PET/CT 18F-FDG PET/CT protocol (positron emission tomography integrated with computed tomography, which uses the glucose radioisotope fluorodeoxyglucose (FDG)) has proven high diagnostic properties in detecting metastases to soft tissues, lymph nodes and internal organs at the stage of initial assessment and during observation and is able to early identify tumor response during TKI treatment (tyrosine kinase inhibitors) [
21].
2. Case Presentation
A 99-year-old patient came for a visit to the Department of Oral Surgery at the University Dental Center of WUM due to gingival problems in the area of teeth 17-16 and 32-33. The patient does not know exactly when the lesions appeared. Their growth and bleeding during food consumption prompted the patient to visit an oral surgeon. He also could not use his dentures. He did not report any pain. Medical history revealed that 4 years ago a nodular lesion of malignant melanoma was detected on the skin of the abdomen. The tumor was removed with a margin of tissue free of the tumor. Histopathological examination: no neuro- or angioinvasion, tumor thickness 4,5mm; mitotic count 8/mm2, no lymphoid cell infiltration. Described as a pT4b stage tumor. CT with contrast did not show other foci of melanoma or suspicious lymph nodes. The patient attended follow-up visits. A year after the MM excision, a recurrence appeared in the postoperative scar: two focal lesions in the scar, which were removed with a margin of tissue free of the tumor. The patient was under constant oncological supervision. CT and ultrasound examinations did not show melanoma metastases.
On the day of presentation to the Department of Oral Surgery, the extraoral examination noted painless, enlarged submandibular lymph nodes on the left side. Intraoral examination revealed the presence of gingival tumors in the area of teeth 17-16 (
Figure 1a) and 32-33 (
Figure 2 and
Figure 3). The lesions were pedunculated, with a narrow pedicle, elastic-hard, irregularly elliptical in shape with impressions of adjacent teeth, pink in color with local hyperemia and white spots. They arose from the marginal gingiva, which was swollen and protruding. The patient had active periodontal disease. The maxillary tumor measured 22 x 10 x 5 mm, the mandibular tumor 30 x 20 x 6 mm and was in close proximity to the teeth. The periodontium was inflamed with the presence of pathological pockets and plaque deposits. Teeth 17, 16, 33 showed grade II mobility. Residual roots of teeth 34, 35 were present. The panoramic radiograph did not show any abnormalities in the bone structure of the tumor area. The patient underwent professional hygiene before surgical treatment due to abundant plaque deposits. Clinically, the image corresponded to reactive hyperplastic lesions, resembling fibrous hyperplasia or pyogenic granuloma.
Under local anesthesia with articaine and norepinephrine 1:200000, the upper gingival tumor was excised within the boundaries of unchanged tissues, teeth 17 and 16 were removed, sharp bone edges were smoothed, and the wound was sutured. The lesion was sent for histopathological examination. Then the lower gingival tumor was completely excised within the boundaries of unchanged tissues, teeth 33, 34 and 35 were removed, sharp bone edges were smoothed, and the wound was sutured. The tissue material was sent for histopathological examination. A week after the tumor excision, the sutures were removed (Fig.1b) and healing proceeded correctly. The patient did not report any complaints.
Histopathological examination result of the upper gingival tumor: polypoid fragment of the mucosa with a focus of neoplastic proliferation composed of small epithelial cells. Immunohistochemical studies (CK Pan (-), Vimentin (+), S100 (+), HMB45(-), LCA(-), Ki67 (+) in 80% of the lesion cells) correspond to a mucosal melanoma focus. Ulceration present. Mitotic index 14/mm
2, including atypical mitoses. Features of regression, angioinvasion, and neuroinvasion: absent. Lymphocytic infiltrates (TILs): present (non-brisk). Satellite nodules: absent. Melanoma tissue is visible at the edges of the examined sections (surgical margin uncertain) (
Figure 4,
Figure 5 and
Figure 6).
Histopathological examination result of the mandibular tumor: lower gingiva. Malignant melanoma within the oral mucosa (OMM). The entire polypoid tissue fragment sent for examination was occupied by neoplastic tissue, which undermined the covering stratified squamous epithelium. The neoplastic tissue reached the basal resection margin of the submitted tissue. Immunohistochemical studies: SOX10(+), MelanA(+), LCA(-), CK Pan(-), high proliferative index Ki67 – 70% confirmed the diagnosis of melanoma. Satellite nodules, features of regression, neuroinvasion, and angioinvasion: absent. Ulceration: present. Mitotic index: 5/mm
2, including atypical mitoses. Lymphocytic infiltrates (TILs): present (non-brisk). Melanoma tissue is visible at the edges of the examined sections (surgical margin uncertain) (
Figure 7–10).
Figure 7.
Immunohistochemical staining MelanA/MART1, objective magnification x10, specimen from the lower gingival tumor.
Figure 7.
Immunohistochemical staining MelanA/MART1, objective magnification x10, specimen from the lower gingival tumor.
Figure 8.
Immunohistochemical staining CKAE1/AE3, objective magnification x10, specimen from the lower gingival tumor.
Figure 8.
Immunohistochemical staining CKAE1/AE3, objective magnification x10, specimen from the lower gingival tumor.
Figure 9.
Immunohistochemical staining SOX10, objective magnification x10, specimen from the lower gingival tumor.
Figure 9.
Immunohistochemical staining SOX10, objective magnification x10, specimen from the lower gingival tumor.
Figure 10.
Hematoxylin and eosin staining, objective magnification x10, specimen from the lower gingival tumor.
Figure 10.
Hematoxylin and eosin staining, objective magnification x10, specimen from the lower gingival tumor.
Genetic test result: no mutation detected in codon 600 of the BRAF gene.
Hematoxylin and eosin staining of the upper gingival tumor specimen (
Figure 4 and
Figure 5) and the lower gingival tumor (
Figure 10) shows a solid neoplastic infiltrate located under the mucosal epithelium, formed by highly atypical, epithelioid melanoma cells. There is a marked polymorphism in the size and shape of both cells and cell nuclei. The nuclei have thickened membranes, chromatin is unevenly dispersed, and large nucleoli are visible. Atypical mitoses are present. The cytoplasm is amphophilic, does not contain pigment (melanin). Numerous neutrophils are present between the neoplastic cells.
In immunohistochemical staining S100 (
Figure 6), a positive nuclear-cytoplasmic reaction is seen in melanoma cells and a negative reaction in stratified squamous epithelial cells. In immunohistochemical staining MelanA/MART1 (
Figure 7) of the mandibular tumor specimen, a positive cytoplasmic reaction is seen in melanoma cells and a negative reaction in stratified squamous epithelial cells. In immunohistochemical staining CKAE1/AE3 (
Figure 8), a negative reaction is seen in melanoma cells and a positive cytoplasmic reaction in stratified squamous epithelial cells. In immunohistochemical staining SOX10 (
Figure 9), a positive nuclear reaction is observed in melanoma cells and a negative reaction in stratified squamous epithelial cells.
The identified melanoma foci within the maxillary and mandibular mucosa may be a new, independent primary focus. After receiving the histopathological results, the patient was urgently referred to the Oncology Center for treatment. Two months after the tumor biopsy, a recurrence was found in the scar after the maxillary tumor excision. CT with contrast was performed. A nodular thickening was visualized in the area of the upper gingiva on the right side, measuring approximately 12 mm. No foci of pathological contrast enhancement were visualized in the direction of metastasis. Lymph nodes (neck, axillary, mediastinal, hilar) were not enlarged. Bones without signs of destruction. The patient was qualified for surgical treatment, which he did not consent to due to the high risk associated with general anesthesia. He was then qualified for radiotherapy (RT).
RT was applied using the VMAT-CBCT technique to the area of melanoma recurrence in the gingiva at a fractional dose of 6Gy to a total dose of 30Gy. The therapy yielded a positive result in the form of tumor regression. It is now 3 months since the completion of RT. At the follow-up visit, no recurrence was observed.
3. Discussion
The melanoma described by us, according to the classification of Tanaka et al., belongs to the non-pigmented nodular type. The tumors had a polypoid form with a narrow stalk, which was atypical.
Our case partially met the ABCDE checklist: there was an irregular shape (feature A), the diameter was greater than 6 mm (feature D), the surface of the tumor protruded above the level of the surrounding epidermis (feature E), but the remaining features were atypical: the edges were smooth and not jagged, with a clear demarcation between it and normal tissues, there was no different coloration.
Using the AEIOU acronym to describe our case, only part of the features fit: A (age: over 50 years), I (irregularity: shape resembles an ellipse, there are imprints of adjacent teeth) and U (ulceration). The atypical features in our case are origin - white race, occurrence - on the gums. Most often, in 80% of cases, it occurs on the palate.
The image was so uncharacteristic that without histopathological examination it would not have been possible to make a correct diagnosis. In the histopathological examination of the preparations of both the upper and lower gums, no angioinvasion or neuroinvasion was found, i.e. melanoma cells did not spread to the circulatory and lymphatic systems. This means lower aggressiveness than cases where such invasion occurs. The mitotic index (MI) is an indicator of how many cells in a given lesion are in the state of mitosis, i.e. undergoing division, per 1 mm2. In the upper gum tumor MI= 14/mm2, and in the lower gum MI= 5/mm2, which means that the melanoma in the jaw was in a more advanced stage. Lymphocytic infiltrates in oral melanoma indicate the body's immune response to the developing tumor. The presence of these infiltrates, called tumor-infiltrating lymphocytes (TIL), can be used to predict the patient's prognosis. Dense lymphocytic infiltrate around melanoma is associated with a better prognosis. In our patient, lymphocytic infiltrates were present, described as moderately abundant (non-brisk). The Ki67 proliferation index is an indicator that measures the rate of division of cancer cells. In melanoma, the Ki67 index is helpful in distinguishing melanoma from benign nevi. The higher the Ki67 index, the greater the risk of metastasis and recurrence. High Ki-67 (60-100%) means that the tumor is developing aggressively. Ki67 in the upper gum preparation was 80%, and in the lower gum 70%, which means a more aggressive lesion in the jaw.
The microscopic image of melanoma in our patient was typical for the amelanotic form: there was cellular pleomorphism, nuclear atypia, atypical mitoses and lack of pigment. Histopathological examination confirmed melanoma in the amelanotic form but does not answer the question whether the examined lesion is primary or metastatic. Melanoma tissue was visible in the margins of the examined sections both in the jaw and in the mandible (uncertain surgical margin), which was associated with a high probability of tumor recurrence. In the jaw, the recurrence appeared quickly, after a few weeks, after 2 months reaching about 50% of the size of the excised tumor.
In our patient, no mutation was detected in codon 600 of the BRAF gene, so targeted therapy could not be used.
Amelanotic oral melanoma is very difficult to diagnose in the early stage, as it is often asymptomatic. An additional difficulty is the anatomical location of the tumor, difficult for the patient to self-assess. Over time, the tumor becomes more and more protruding and irregular, bleeding during meals. Ulceration of the surface may occur. It can be mistaken for benign tumors or squamous cell carcinomas.
In the differential diagnosis of amelanotic melanomas Kaposi's sarcoma, pyogenic granuloma, salivary gland tumors, lymphomas, and even hematomas should be considered - especially in patients taking anticoagulants [
5]. If the pigmentation of the lesion cannot be definitively diagnosed as benign based on clinical evidence, biopsy is mandatory to exclude OMM.
The collected history, however, required special oncological vigilance in this case. Our patient had active periodontal disease, which suggested a lesion on an inflammatory basis. In the presented case, the clinical picture of the lesions deviated from the typical characteristics of oral mucosal melanomas, suggesting the presence of gingival proliferative lesions. Similar appearancehave inflammatory fibrous hyperplasia, pyogenic granuloma, fibrous epulis, peripheral giant cell granuloma or eosinophilic granuloma. However, in these cases, unlike oral melanoma, the factors leading to their development are calculus and dental plaque, sharp fillings or tooth edges and other irritating factors. Differentiating amelanotic melanoma from other conditions listed above can be difficult, so histopathological examination is crucial.
Inflammatory fibrous hyperplasia (IFH) is a common reactive lesion of the oral mucosa. Clinically, it often presents as a well-defined exophytic lesion with firm consistency and normal gum color. It can be soft or hard on palpation. Histologically, inflammatory fibrous hyperplasia consists of a mass of hyperplastic connective tissue with dilated blood vessels, usually with chronic inflammatory cells such as lymphocytes and plasma cells but can also be composed of solid connective tissue with minimal or no inflammatory cells [22, 23].
The primary method of treatment for patients with oral mucosal melanoma is radical surgical excision within healthy tissue margins. Guidelines for the surgical treatment of primary skin melanoma recommend diagnostic excisional biopsy, and then after obtaining the diagnosis, excision of the scar with an appropriately wide margin of macroscopically unchanged tissues. In the oral cavity, the size of the lesion and anatomical limitations may make it difficult to perform an excisional biopsy. Younes et al. proposed excisional biopsy with a margin of 1-2 mm for small lesions, while for large tumors or those located in places where excision would involve extensive and mutilating surgery, they suggest incisional biopsy through the thickest or most suspicious part of the tumor [
6]. According to the guidelines of the National Comprehensive Cancer Network (NCCN, U.S.A.), the primary treatment should be surgical for stage III to IVA in the AJCC TNM classification (
Table 1), and surgery is not recommended in stages IVB and IVC - such patients should be referred for clinical trials or radiotherapy [
25].
In the diagnosis of OMM, as in the case of squamous cell carcinoma, local resection should be combined with appropriate reconstruction of mandibular or soft tissue deficits using free flaps. Since distant disease ultimately develops in most patients (50-90%) regardless of the wide margins of the primary surgical procedure, patient preferences and quality of life considerations are crucial in determining the extent of resection [
26]. Recurrences can be explained by the presence of atypical melanocytes in the surgical margins and/or the presence of satellite nodules [
6].
Unlike skin melanoma, where randomized clinical trials have been conducted to determine the optimal width of tumor-free margins, there are no guidelines for the surgical treatment of OMM. Umeda and Shimada recommend resection with a margin of at least 1,5 cm of healthy tissue [
6]. Zitelli et al. additionally stated that the safety margin should be at least 2,5 cm for melanomas with a diameter greater than 3 cm [
4].
Radiotherapy improves local control but does not affect overall survival (OS). Currently, there is no fully effective systemic treatment for these patients (the results of systemic treatment of mucosal melanoma are significantly worse compared to skin melanoma), which justifies the search for new methods [
1]. Radiotherapy may be useful in cases where surgical treatment is not possible, for example in patients with severe general diseases or to improve local tumor control and reduce distant metastases [
24]. New treatment methods for patients with OMM include combinations of immunotherapy or immunotherapy and local therapies. Few cases of successful treatment with peritumoral injections of interferon beta (IFN-b) and interleukin 2 (IL-2) in combination with nivolumab have been described. Targeted therapy, including BRAF/MEK or KIT inhibitors (imatinib), can be considered in carriers of appropriate mutations [
1], which in the case of oral mucosal melanoma can be found in a dozen percent of patients.
Neck lymph node dissection is necessary in every case of their involvement by metastatic oral melanoma. About 50% of patients who did not have regional metastases at the time of diagnosis eventually develop lymph node metastasis, so elective dissection is recommended for most patients [
5].
4. Conclusions
Diagnosis of the amelanotic form of melanoma is not easy, as in the early stage it does not give specific clinical symptoms.
All proliferative lesions occurring in the oral cavity in people treated for melanoma should be potentially treated as another focus or metastasis of melanoma. If the size of the lesion allows, it should be excised completely with a margin of 1-2 mm and absolutely sent for histopathological examination.
Oncological vigilance should be raised by any asymmetrical and irregular outline of the lesion, uneven distribution of pigmentation, evolution in thickness and surface, as well as a diameter exceeding 6 mm. Especially if the lesion is accompanied by ulceration and occurs in older people.
If, however, melanin is not present in amelanotic melanoma, immunohistochemical staining should be performed to obtain further information.
For long-term survival, early diagnosis of the tumor and radical surgical removal are crucial. Due to the high risk of recurrence, patients with oral melanoma in their history require lifelong observation.
Author Contributions
WP: conceptualization and writing-review and editing, project administration, supervision; KP: investigation and writing-review; MS, MM: formal analysis and visualization; MM, KP: writing – original draft preparation. All authors read and agreed to the published version of the manuscript.
Funding
This research received no external funding.
Informed Consent Statement
The patient gave informed, written consent to the proposed treatment and the use of the treatment results for scientific and teaching purposes. This work was carried in compliance with clinical ethical rules. Clinical trial number: not applicable
Conflicts of Interest
The authors declare that they have no competing interests.
References
- Napierała, Marcin J. and Czarnecka, Anna M., 2019. Mucosal melanoma – clinical presentation and treatment based on a case series. Oncology in Clinical Practice. 2019. Vol. 15, p. 223–230. [CrossRef]
- Reddy BV, Sridhar GR, Anuradha CH, Chandrasekhar P, Lingamaneni KP. Malignant melanoma of the mandibular gingiva: a rare occurrence. Indian J Dent Res. 2010 Apr-Jun;21(2):302-5. [CrossRef] [PubMed]
- Hsiao, Kai-Yuan, et al. "Oral mucosa malignant melanoma: Clinical features, diagnosis, treatment, and a case report." Journal of Dental Problems and Solutions 2.2 (2015): 019-024.
- Pradhan P, Adhya AK. Extensive malignant melanoma of the oral cavity: a rare occurrence. Autops Case Rep. 2021 Aug 20;11:e2021299. [CrossRef] [PubMed] [PubMed Central]
- Feller, Liviu, Khammissa, Razia A. G., Lemmer, Johan, A Review of the Aetiopathogenesis and Clinical and Histopathological Features of Oral Mucosal Melanoma, The Scientific World Journal, 2017, 9189812, 7 pages, 2017.
- Meleti M, Leemans CR, Mooi WJ, Vescovi P, van der Waal I. Oral malignant melanoma: a review of the literature. Oral Oncol. 2007 Feb;43(2):116-21. [CrossRef] [PubMed]
- Khalifa H, Abdullah S, Sallam K, Khalil H, Moneim IA, Elaffandi A. Primary malignant melanoma of the tongue. Can J Surg. 2009 Dec;52(6):E309-11. [PubMed] [PubMed Central]
- Keraliya AR, Krajewski KM, Braschi-Amirfarzan M, Tirumani SH, Shinagare AB, Jagannathan JP, Ramaiya NH. Extracutaneous melanomas: a primer for the radiologist. Insights Imaging. 2015 Dec;6(6):707-17. [CrossRef] [PubMed] [PubMed Central]
- Santos RS, Andrade MF, Alves Fde A, Kowalski LP, Perez DE. Metastases of Melanoma to Head and Neck Mucosa: A Report of Short Series. Clin Exp Otorhinolaryngol. 2016 Mar;9(1):80-4. [CrossRef] [PubMed] [PubMed Central]
- Antoine Thuaire, Romain Nicot, Marie Boileau, Gwénaël Raoul, Clothilde Descarpentries, François Mouawad, Nicolas Germain, Laurent Mortier, Matthias Schlund, Oral mucosal melanoma – A systematic review, Journal of Stomatology, Oral and Maxillofacial Surgery, Volume 123, Issue 5, 2022, Pages e425-e432, ISSN 2468-7855.
- Billings KR, Wang MB, Sercarz JA, Fu YS. Clinical and pathologic distinction between primary and metastatic mucosal melanoma of the head and neck. Otolaryngol Head Neck Surg. 1995 Jun;112(6):700-6. [CrossRef] [PubMed]
- Baranovic S, Milenovic A. Melanoma metastasis to the oral cavity: a rare case report and literature review. J Clin Investig Surg. 2022;7(1):100-103. [CrossRef]
- Barabás J, Suba Z, Szabó G, Ujpál M. Melanoma malignummetastásisok a szájüregben [Malignant melanoma metastasis in the oral cavity]. FogorvSz. 2006 Aug;99(4):149-52. Hungarian. [PubMed]
- Sharma Lamichhane, N., An, J., Liu, Q. et al.Primary malignant mucosal melanoma of the upper lip: a case report and review of the literature. BMC Res Notes8, 499 (2015).
- Xavier-Junior JCC, Ocanha-Xavier JP, Asato MA, Bernabé DG. The 'AEIOU' system to identify primary oral melanoma. Oral Oncol. 2022 Jan;124:105670. [CrossRef] [PubMed]
- Warszawik-Hendzel O, Słowińska M, Olszewska M, Rudnicka L. Melanoma of the oral cavity: pathogenesis, dermoscopy, clinical features, staging and management. J Dermatol Case Rep. 2014 Sep 30;8(3):60-6. [CrossRef] [PubMed] [PubMed Central]
- Jou A, Miranda FV, Oliveira MG, Martins MD, Rados PV, Filho MS. Oral desmoplastic melanoma mimicking inflammatory hyperplasia. Gerodontology 2012 Jun;29(2):e1163-7. [CrossRef] [PubMed]
- Adisa AO, Olawole WO, Sigbeku OF. Oral amelanotic melanoma. Ann Ib Postgrad Med. 2012 Jun;10(1):6-8. [PubMed] [PubMed Central]
- Devi P, Bhovi T, Jayaram RR, Walia C, Singh S. Malignant melanoma of the oral cavity showing satellitism. J Oral Sci. 2011 Jun;53(2):239-44. [CrossRef] [PubMed]
- Mendenhall WM, Amdur RJ, Hinerman RW, Werning JW, Villaret DB, Mendenhall NP. Head and neck mucosal melanoma. Am J Clin Oncol. 2005 Dec;28(6):626-30. [CrossRef] [PubMed]
- Aide, N., Iravani, A., Prigent, K. et al. PET/CT variants and pitfalls in malignant melanoma. Cancer Imaging 22, 3 (2022).
- Da Silva Barros, C. C.; Medeiros, M. R. S.; Rego, D. M.; Miguel, M. C. C.; Da Silveira, É. J. D. Inflammatory fibrous hyperplasia associated with chondroid metaplasia Report and morphological analysis of five cases. Int. J. Odontostomat., 17(1):101-106, 2022.
- Shukla P, Dahiya V, Kataria P, Sabharwal S. Inflammatory hyperplasia: From diagnosis to treatment. J Indian Soc Periodontol. 2014 Jan;18(1):92-4. [CrossRef] [PubMed] [PubMed Central]
- Barata B, Freitas F, Vilares M, Caramês J, Oral mucosal melanoma: A systematic review of case reports and case series, Journal of Oral and Maxillofacial Surgery, Medicine, and Pathology, Volume 36, Issue 3, 2024, Pages 388-395, ISSN 2212-5558.
- Bezerra Toscano de Mendonça U, Guimarães Soffientini J, Ficher Barbosa V, Cozer K. Mucosal Melanoma of the Head and Neck: From Diagnosis to Treatment [Internet]. Melanoma. IntechOpen; 2021.
- Carvajal RD, Spencer SA, Lydiatt W. Mucosal melanoma: a clinically and biologically unique disease entity. J Natl ComprCancNetw 2012; 10:345.
- Karp P, Lewkowicz N, Żebrowska A. Mucosal melanoma – diagnostic challenge. Dermatology Review/Przegląd Dermatologiczny. 2024;111(1):31-38. [CrossRef]
|
Disclaimer/Publisher’s Note: The statements, opinions and data contained in all publications are solely those of the individual author(s) and contributor(s) and not of MDPI and/or the editor(s). MDPI and/or the editor(s) disclaim responsibility for any injury to people or property resulting from any ideas, methods, instructions or products referred to in the content. |
© 2025 by the authors. Licensee MDPI, Basel, Switzerland. This article is an open access article distributed under the terms and conditions of the Creative Commons Attribution (CC BY) license (http://creativecommons.org/licenses/by/4.0/).